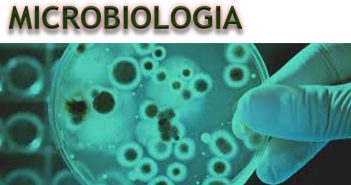

Protegido: Microbiologia – Biomedicina P3 – FASER – 2018.2
Este conteúdo está protegido por senha. Para vê-lo, digite sua senha abaixo: Senha:
Este conteúdo está protegido por senha. Para vê-lo, digite sua senha abaixo: Senha:

Este conteúdo está protegido por senha. Para vê-lo, digite sua senha abaixo: Senha:

Este conteúdo está protegido por senha. Para vê-lo, digite sua senha abaixo: Senha:

Este conteúdo está protegido por senha. Para vê-lo, digite sua senha abaixo: Senha:

Este conteúdo está protegido por senha. Para vê-lo, digite sua senha abaixo: Senha:

Este conteúdo está protegido por senha. Para vê-lo, digite sua senha abaixo: Senha:

Este conteúdo está protegido por senha. Para vê-lo, digite sua senha abaixo: Senha:

Este conteúdo está protegido por senha. Para vê-lo, digite sua senha abaixo: Senha:

Este conteúdo está protegido por senha. Para vê-lo, digite sua senha abaixo: Senha: